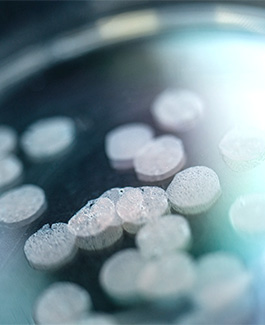
Petri dish

Innovation, discovery and translational research
Driven by a relentless pursuit of innovation, our globally acclaimed research leaders and their dedicated teams are committed to discovering breakthroughs that pave the way for next-generation drugs, vaccines, and diagnostics. Through translational research, they transform their findings into meaningful advancements, significantly improving community health outcomes worldwide.
Our major research themes
Cancer
Cancer is a significant global health issue and a leading cause of death worldwide. Our specialists are exploring a wide range of treatments, tackling challenges such as drug resistance, and advancing diagnostic technologies for various cancers including breast, ovarian, prostate, lymphoma, melanoma, sarcoma, head and neck, lung, rare cancers and brain tumours. Our research and key clinical collaborators place us at the cutting edge of cancer glycomics, a field that examines the interactions between sugar molecules and proteins on the surface of cancer cells. Our researchers are leveraging this innovative approach to discover new solutions for cancer diagnosis and treatment.
Infectious diseases
Infectious diseases remain among the most significant global health challenges, claiming millions of lives each year. New strategies are urgently needed to combat illnesses caused by bacterial, viral, parasitic and fungal pathogens, and the growing threat of antibiotic resistance intensifies this concern. Our experts are advancing innovative approaches to address antibiotic resistance, the emergence of new pathogens with pandemic potential, and the shortage of effective vaccines for serious diseases including rheumatic heart disease caused by Streptococcal A infection, gonorrhoea, HIV-1 , influenza, hPIV , SARS‑CoV‑2 , RSV , Ross River virus, chikungunya virus and malaria.
Neurological conditions
Neurological conditions are characterised by the progressive degeneration of the structure and function of the central and peripheral nervous systems, leading to issues with movement and mental function. As the global population ages, the number of people affected by these conditions is expected to rise. Our experts are addressing conditions such as spinal injury, neurodegeneration, peripheral nerve repair, axon degeneration, Parkinson’s disease, mental health, PTSD and pain. Their goal is to deliver solutions that significantly improve the quality of life for individuals with diseases and injuries of the nervous system.
Our emerging research themes
Healthy ageing
As life expectancy increases, the burden of age related disease continues to grow. Cancer, neurodegenerative conditions and increased susceptibility to, and chronic diseases arising from infection are all closely linked to ageing. The Institute will coordinate and expand ageing related research across its existing themes while developing new avenues to understand the genetic, molecular, cellular and biochemical changes associated with ageing. This work will inform strategies to promote long term health and resilience, with direct relevance to local communities and broad global significance. Healthy ageing will also be a focal area for community.
Indigenous health
Significant disparities in health outcomes and life expectancy persist for many Aboriginal and Torres Strait Islander peoples. The Institute is committed to contributing to efforts to close this gap through the development of preventative, diagnostic and therapeutic innovations that are relevant and responsive to Indigenous health priorities. Extending the Institute’s portfolio of novel candidate medicines into this area will position it among a small number of biomedical research institutes with a dedicated focus on Indigenous Health. Meaningful and respectful engagement with Indigenous communities will underpin this work, ensuring research translation addresses community identified needs and supports improved health outcomes.
Our centres of research excellence

NHMRC Centre of Research Excellence in Vaccine Adjuvant Discovery and Development – Vaccine-ADD
Fraunhofer Item & Institute for Biomedicine and Glycomics Joint Laboratory for Anti-infective Research
Research experts
Our world-class researchers work with industry, community and government partners to better understand our world and improve people’s lives
Clinical trials
Translational clinical studies, including clinical trials, test laboratory-based findings in volunteer participants. Depending on the research aim, studies may involve collecting and analysing samples from individuals with specific diseases, evaluating the performance and effectiveness of new diagnostic tests, or assessing the effectiveness of new interventions, such as experimental drugs or vaccines. Griffith University's Clinical Trial Unit offers translational research services to Griffith staff and students, professional site services to commercial clients, and opportunities for individuals to participate in clinical research in a supportive and safe environment.
Study with us
Study alongside some of the world's most experienced and well-known research leaders and scientists and help us fight for a healthier future for all.
Latest news
New biotech partnership to deliver advances in biomedical technology
21 May 2026
Intelligene will set up a home base at Griffith University to work in partnership with researchers...
No refrigeration needed for killer disease vaccine
13 May 2026
A new vaccine is showing promise as it not only offers long-lasting strong protection but also...
New spin-out to make life-saving medicines more affordable
13 May 2026
A new Griffith University spin-out company has been established to develop innovative technology to...
Funding boost for traumatic brain injury research
06 May 2026
A Griffith University research project aimed at developing future therapies for people living with...
Vaccine research at the heart of new Centre of Research Excellence
15 Apr 2026
Improving vaccines targeted at keeping the community safe and healthy will be the core focus of...
Seaweed has the potential to create a shield to block norovirus infection
11 Mar 2026
Seaweed may be a popular food item, but it has certain properties which have the ability to create...
Contact us
Institute for Biomedicine and Glycomics
Griffith University
1 Parklands Dr
Southport QLD 4215
170 Kessels Rd
Nathan QLD 4111






